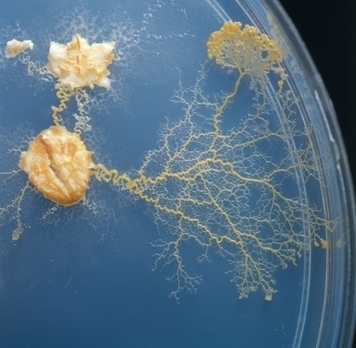

Bill Bailey Theremin Jellyfish
Don giller recommended.

Bill bailey theremin jellyfish. 50 videos play all mix bill bailey essential guide to the orchestra live at the o2 dublin the jellyfish youtube monty python on letterman part 2. This page has been listed as needing cleanup since 2007 01 28. We bumped into bill bailey and asked him to play theremin bollards he needed no encoragement. One of the night was broadcast last week.
We bumped into bill bailey and had a quick chat and asked him to play on theremin bollards bill happily obliged. Interestingly he did a 5 minute section just about the theremin and a piece called the jellyfish. At the launch of wonderlab at the science museum london. Bill bailey and theremin bollards had finally met and had a great time.
Filmed at hammersmith apollo london in 2004. Argos clip taken from part troll dvd. Clip from the tinselworm dvd by bill bailey. Bill bailey plays theremin bollards.
Last year he did three nights at the royal albert hall with the bbc concert orchestra introducing classical music. This person article needs cleanup. Shocking claims of human jellyfish babies surface after the release of archive spare rib interviews. Bill bailey played droxil a harvest ranger from the planet androzani major in the 2011 christmas special of doctor who titled the doctor the widow and the wardrobe.
Filmed at hammersmith apollo london in 2004. In 2009 bailey presented a project about the explorer and naturalist alfred russel wallace in the form of an indonesian travelogue. Bill bailey is a british comedian who incoporates a lot of music into his comedy. Strictly come dancings bill bailey mourns old friend as pet dog banjar dies.
Zippedee do dah clip taken from part troll dvd.


:format(jpeg):mode_rgb():quality(40)/discogs-images/R-754330-1155421549.jpeg.jpg)

:format(jpeg):mode_rgb():quality(40)/discogs-images/A-263416-1185885411.jpeg.jpg)





































